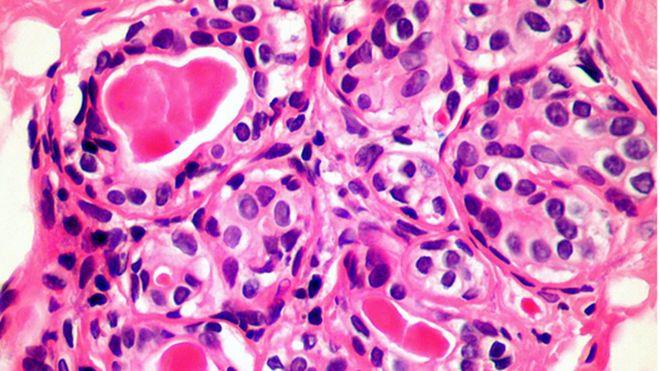

Премьер Польши из-за плотного графика отменил частный визит в Литву
Польский премьер Матеуш Моравецкий отменил запланированный на пятницу частный визит в Литву, подтвердил пресс-атташе премьера Литвы Саулюса Сквернялиса. "Визит отменен) из-за плотного графика и важных голосований в парламенте страны", – сказал BNS Томас Бержинскас.